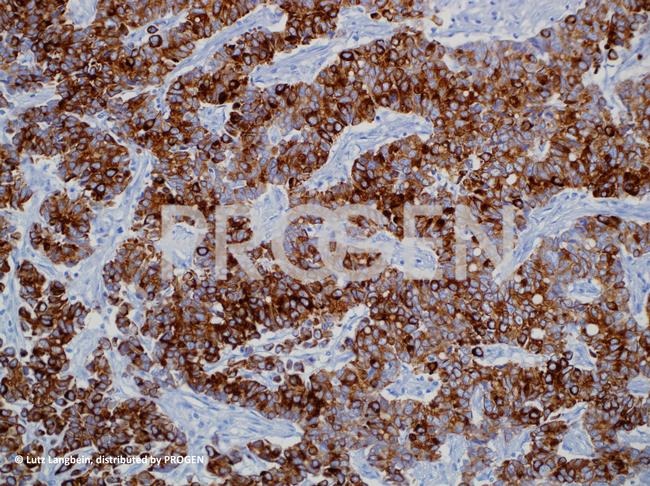
Cytokeratin 20 Antibody in Immunohistochemistry (IHC)

Search
Progen
Cytokeratin 20 Monoclonal Antibody (IT-Ks20.8)
{{$productOrderCtrl.translations['antibody.pdp.commerceCard.promotion.promotions']}}
{{$productOrderCtrl.translations['antibody.pdp.commerceCard.promotion.viewpromo']}}
{{$productOrderCtrl.translations['antibody.pdp.commerceCard.promotion.promocode']}}: {{promo.promoCode}} {{promo.promoTitle}} {{promo.promoDescription}}. {{$productOrderCtrl.translations['antibody.pdp.commerceCard.promotion.learnmore']}}
产品信息
61026PROGEN
种属反应
宿主/亚型
分类
类型
克隆号
抗原
偶联物
形式
浓度
纯化类型
保存液
内含物
保存条件
运输条件
产品详细信息
Reconstitute lyophilized product with 1 mL distilled water.
IT-Ks 20.8 represents an excellent marker for certain types of carcinomas such as adenocarcinomas of the colon, transitional cell carcinomas of the bladder and Merkel cell tumors of the skin. Very sensitive detection of intestinal and gastric foveolar epithelium, urothelial umbrella cells, Merkel cells of epidermis as well as tumors originating therefrom (e.g. primary and metastatic colorectal carcinoma). Adenocarcinomas of breast, lung, endometrium and ovary (non-mucinous) as well as neuroendocrine tumors of the lung are essentially negative. Polypeptide recognized: protein IT (keratin K20; MW 46 000; formerly also designated cytokeratin 20).Tested cultured cell lines: RT-4.
靶标信息
The protein encoded by this gene is a member of the keratin family. The keratins are intermediate filament proteins responsible for the structural integrity of epithelial cells and are subdivided into cytokeratins and hair keratins. The type I cytokeratins consist of acidic proteins which are arranged in pairs of heterotypic keratin chains. This cytokeratin is a major cellular protein of mature enterocytes and goblet cells and is specifically expressed in the gastric and intestinal mucosa. The type I cytokeratin genes are clustered in a region of chromosome 17q12-q21.
仅用于科研。不用于诊断过程。未经明确授权不得转售。
篇参考文献 (0)
生物信息学
蛋白别名: CK-20; cytokeratin 20; Cytokeratin-20; K20; keratin 20, type I; Keratin, type I cytoskeletal 20; Keratin-20; krt20; MGC35423; Protein IT
基因别名: 9030623C06Rik; CD20; CK-20; CK20; K20; KRT20; KRT21
UniProt ID: (Human) P35900, (Mouse) Q9D312
Entrez Gene ID: (Human) 54474, (Mouse) 66809